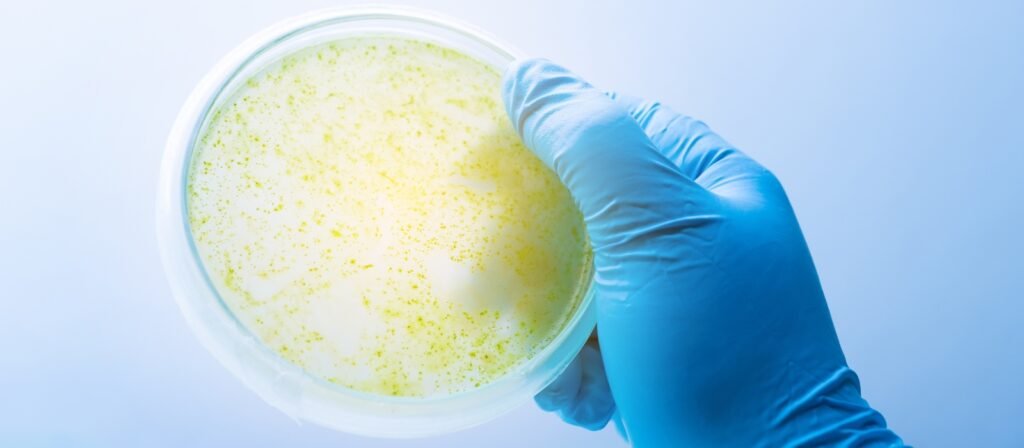

Guia de Uso: Como preparar meios de cultura com balança analítica e agitador magnético
No cenário microbiológico, a qualidade dos resultados obtidos em testes depende diretamente da preparação correta dos insumos utilizados. Dentre eles, os meios de cultura ocupam uma posição central. São eles que fornecem os nutrientes necessários para o crescimento de microrganismos em análises clínicas, ambientais, alimentares e farmacêuticas. Para garantir a confiabilidade desses ensaios, é fundamental dominar as boas práticas para preparar meios de cultura, utilizando equipamentos laboratoriais adequados como balança analítica e agitador magnético.
Este guia técnico tem como objetivo orientar profissionais de laboratório sobre as etapas essenciais para o preparo correto de meios de cultura, destacando o papel da precisão da pesagem e da homogeneização eficiente das soluções.

Por que a precisão é fundamental ao preparar meios de cultura?
A formulação de um meio de cultura exige a adição exata de componentes como peptonas, extratos, açúcares, agentes tamponantes e sais minerais. Qualquer variação nessas proporções pode comprometer a seletividade ou a capacidade nutritiva do meio, afetando diretamente a reprodutibilidade dos resultados microbiológicos.
Nesse contexto, preparar meios de cultura com o auxílio de uma balança analítica se torna imprescindível, pois esse equipamento oferece altíssima precisão na pesagem, geralmente na ordem de 0,1 mg (0,0001 g). Isso garante que mesmo os componentes adicionados em quantidades mínimas estejam dentro da faixa correta especificada nas formulações padronizadas, como as descritas nas farmacopeias ou normas ISO/ANVISA.
Equipamentos recomendados
Para otimizar o preparo dos meios de cultura, dois equipamentos são essenciais:
1. Balança analítica
-
Precisão: entre 0,1 mg a 0,01 mg.
-
Função principal: pesar componentes químicos com alta acurácia.
-
Boas práticas:
-
Calibrar regularmente.
-
Evitar correntes de ar e vibrações.
-
Usar pinças e espátulas de aço inox ou PTFE.
-
2. Agitador magnético com aquecimento
-
Função principal: dissolver os componentes químicos no meio líquido (geralmente água destilada ou deionizada), mantendo temperatura controlada.
-
Boas práticas:
-
Utilizar barras magnéticas revestidas.
-
Controlar temperatura (em geral entre 40 °C e 60 °C).
-
Ajustar a rotação para garantir homogeneidade sem formação de espuma.
-
Esses dois equipamentos, quando bem utilizados, tornam o processo de preparar meios de cultura mais seguro, reprodutível e eficiente.
Passo a passo: Como preparar meios de cultura com balança analítica e agitador magnético
Abaixo, um protocolo técnico de referência para laboratórios microbiológicos:
1. Escolha do meio de cultura
Antes de iniciar, defina o meio necessário: ágar nutritivo, caldo tripticaseína-soja (TSB), MacConkey, Ágar Sabouraud, entre outros. Consulte a formulação do fabricante ou compêndios oficiais.
2. Calcule a quantidade necessária
Geralmente, os fabricantes indicam o preparo em gramas por litro (ex: 40 g/L). Se o laboratório precisa de 500 mL, a regra de três simples ajuda:
Exemplo:
40 g → 1000 mL
X g → 500 mL
X = 20 g
3. Pese os componentes na balança analítica
-
Ligue a balança, calibre se necessário.
-
Use um recipiente de pesagem adequado (vidro ou plástico antieletrostático).
-
Pese os componentes individualmente.
-
Anote todas as pesagens no caderno de registros ou planilha digital.
4. Adicione os componentes à água
-
Use água destilada ou deionizada.
-
Coloque parte da água (aproximadamente 80%) no béquer.
-
Ative o agitador magnético e insira a barra magnética.
-
Adicione gradualmente os componentes sob agitação.
-
Mantenha o aquecimento entre 45 °C e 60 °C até total dissolução.
5. Completar volume
Após total dissolução, complete o volume com a água restante até atingir o valor desejado (ex: 500 mL ou 1000 mL).
6. Verifique o pH
Alguns meios exigem pH específico. Ajuste com solução de NaOH ou HCl, se necessário, e verifique com pHmetro previamente calibrado.
7. Filtrar ou autoclavar
-
Se o meio for sensível ao calor, utilize filtragem estéril.
-
Caso contrário, esterilize em autoclave a 121 °C por 15 minutos (condições padrão da maioria dos meios).
8. Armazenamento ou vertimento
-
Após esterilização, resfrie até 45 °C para verter em placas de Petri.
-
Armazene em frascos âmbar ou sob refrigeração, conforme especificação do fabricante.

Benefícios de usar equipamentos adequados para preparar meios de cultura
-
Padronização dos ensaios: com a pesagem precisa e homogeneização controlada, o desempenho do meio é replicável.
-
Redução de erros humanos: equipamentos automatizados evitam variações manuais.
-
Eficiência no tempo de preparo: o agitador magnético acelera a dissolução, tornando o processo mais ágil.
-
Segurança microbiológica: meios corretamente preparados reduzem o risco de contaminação cruzada ou falsos negativos.
Cuidados durante o preparo
Ao preparar meios de cultura, é essencial manter o ambiente limpo e os materiais esterilizados, especialmente quando se trata de aplicações clínicas e alimentares. Entre os cuidados adicionais:
-
Utilizar EPI (luvas, jaleco, óculos de proteção).
-
Trabalhar sob capela de fluxo laminar, se disponível.
-
Registrar o lote do meio, data de preparo e validade.
-
Não reutilizar meios fora do prazo de validade ou contaminados.
Legislação e boas práticas
No Brasil, o preparo de meios de cultura deve seguir orientações como:
-
RDC 275/2002 – Boas Práticas de Laboratório (ANVISA).
-
ISO 11133:2014 – para avaliação de desempenho e controle de qualidade de meios de cultura microbiológicos.
-
Farmacopeia Brasileira – para preparações utilizadas em análises clínicas e farmacêuticas.
Estar em conformidade com essas diretrizes é uma exigência tanto para laboratórios acreditados quanto para instituições de pesquisa.
Conclusão: Profissionalize o preparo do seu meio de cultura
Ao entender como preparar meios de cultura com o apoio técnico da balança analítica e do agitador magnético, o laboratório ganha em confiabilidade, segurança e produtividade. O domínio dessa etapa é o que sustenta análises microbiológicas robustas, garantindo que os resultados reflitam com precisão a realidade das amostras testadas.
Se sua equipe ainda realiza esse processo de forma manual e imprecisa, é hora de investir em equipamentos de alta performance e treinamentos adequados.
Quer otimizar o preparo dos seus meios de cultura com equipamentos de precisão?
Fale com nossos especialistas e conheça as soluções SPLABOR em balanças analíticas e agitadores magnéticos para laboratórios de microbiologia.

A Splabor é uma empresa líder no ramo de fabricação de equipamentos para laboratório, especializada em oferecer uma ampla variedade de equipamentos para laboratórios, materiais e produtos para laboratório de alta qualidade.